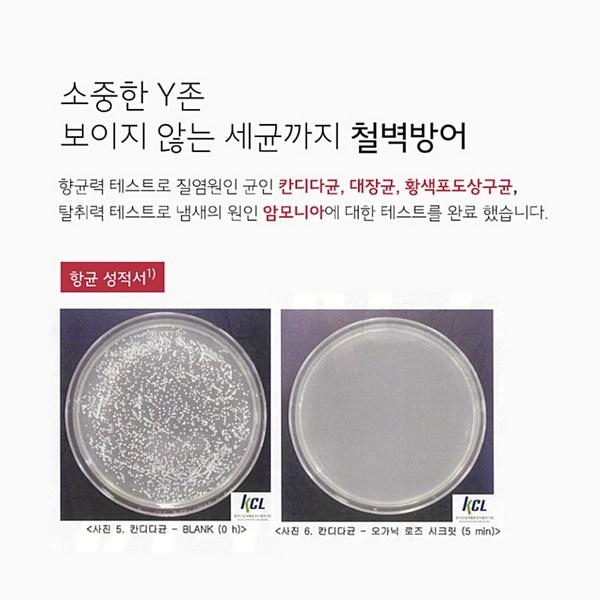

Le site n'est pas supporté par votre navigateur. Veuillez mettre à jour le navigateur ou télécharger un autre
The Aroma Shop vaginite Candida Yn Zone antibactérien saupoudrer 99,9% du nettoyage des femmes, 100 ml, 2 pièces cosmétiques coréens
Prix actuel
Prix 52 €TVA incluse
Prix 26 € / pcs
Couleur
Comme sur l'imageLivraison partout en 🇦🇹 Autriche
Livraison 11‑24 jours ouvrables
Vos paiements et votre confidentialité sont en sécurité









Produits similaires

![[Capacité totale 200 ml grande capacité] V&A Brume Éclat Antioxydante 100 ml double spécial, cosmétiques coréens](https://img.joomcdn.net/c167e2639c9bfe455b0320f48f0125c53f2f3c62_100_100.jpeg)










